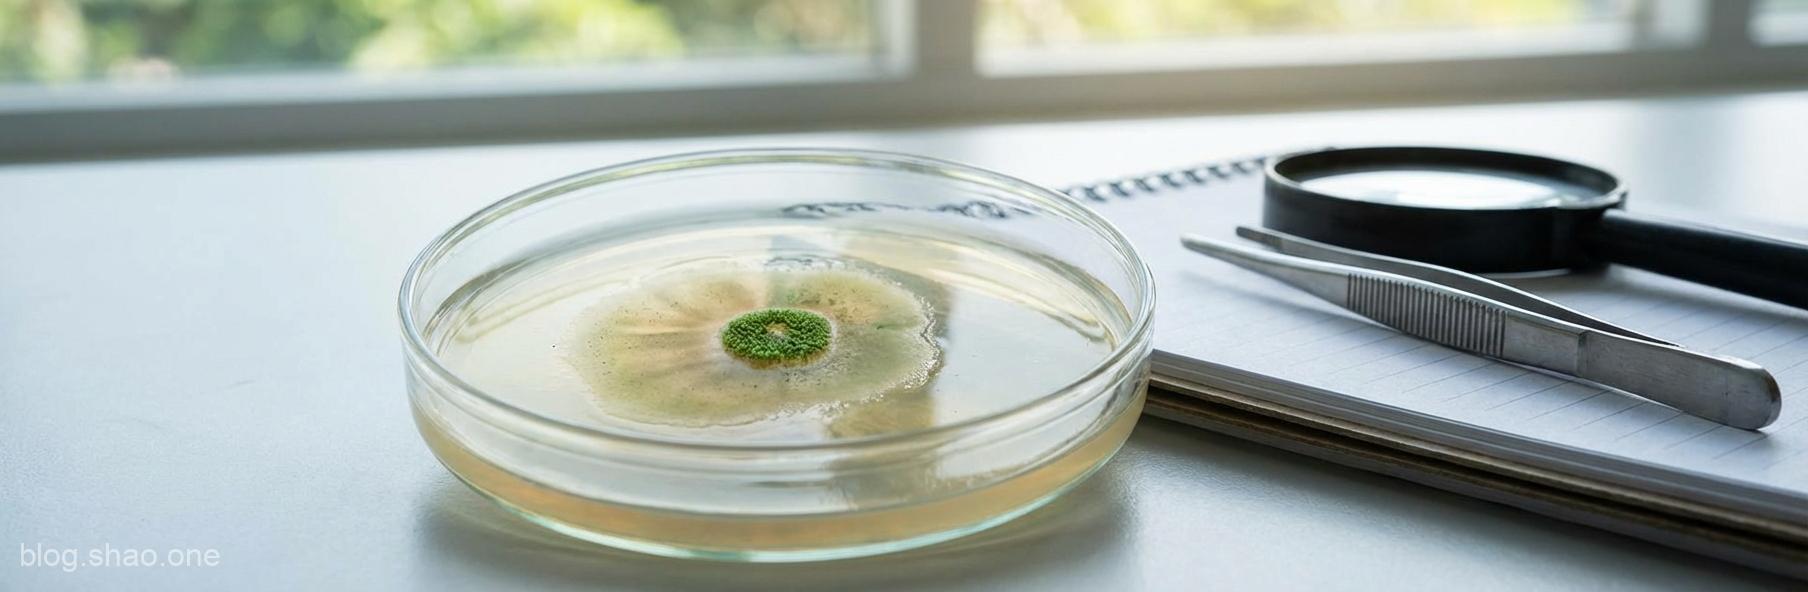
1766750758460

前言:鳳凰涅槃,不只是傳說
在許多神話故事中,「鳳凰浴火重生」象徵著在毀滅中尋找新生。但在現實的生物醫學領域,這並非虛構。長期以來,科學家一直觀察到一種奇特的現象:當我們的皮膚或內臟器官的上皮組織(Epithelial tissue)遭受嚴重損傷時,剩下的健康細胞會突然「爆發式」地生長,以填補空缺。這種現象被稱為「補償性增生」(Compensatory Proliferation)。
這聽起來雖然很神奇,但過去 50 年來,科學界對於這種「打不倒的生命力」背後的具體機制,一直處於一種「霧裡看花」的狀態。直到最近,一項刊登在《Phys.org》的研究終於撥雲見日,為我們揭開了這個隱藏在細胞深處的奧秘。
跨越半世紀的挑戰:為什麼這項研究如此重要?
這項研究的意義不僅僅在於「補強」了教科書的內容,更是生物學界一項「破天荒」的進展。以下是本次發現的三大關鍵亮點:
- 終結長達 50 年的懸案: 自 1970 年代以來,科學家就觀察到細胞死亡會誘導周圍細胞分裂,但其分子訊號傳導路徑始終像是一場「羅生門」,各方說法不一。
- 揭露「細胞間的悄悄話」: 研究發現,垂死的細胞在嚥下最後一口氣前,會釋放特定的蛋白質訊息,告訴鄰居:「我不行了,接下來看你們表演了!」
- 醫療應用的潛力無限: 了解這套機制,意味著未來我們可能人工誘導組織再生,這對於慢性傷口癒合、器官損傷修復甚至是癌症治療,都有著「點石成金」般的啟發意義。
深入解密:細胞是如何實現「脫胎換骨」的?
根據研究顯示,這套機制的核心在於上皮組織的應激反應。當組織遭受大面積破壞時,原本處於安穩狀態的細胞會感受到環境壓力的劇烈變化。這時,受損細胞會啟動一系列複雜的生化反應,釋放出多種細胞因子。
這就像是原本平靜的社區突然發生了火災(組織受損),消防隊(再生機制)會立刻出動。有趣的是,研究指出這種再生並非漫無目的地生長,而是一場精密的「按部就班」。細胞會根據受損的程度,精確計算需要分裂的次數,直到組織恢復原狀。這種精確度讓人不禁感嘆大自然的鬼斧神工,真是「薑還是老的辣」,演化機制遠比人類設計的任何系統都要精密。
科技評論:這對未來的我們有什麼影響?
這項研究成果對一般大眾而言,絕對不是「紙上談兵」。想像一下,如果我們能掌握這把開啟再生大門的鑰匙:
- 糖尿病患者的福音: 許多糖尿病患者面臨傷口難以癒合的困境,未來或許能透過激活補償性增生路徑,讓傷口「藥到病除」。
- 抗老與美容科技: 雖然目前還言之過早,但理解皮膚再生的終極機制,無疑為未來的抗老醫學鋪平了道路。
- 癌症研究的新方向: 癌症本質上就是細胞的不受控增生。如果我們搞清楚了補償性增生的「煞車」與「油門」,對於阻斷癌細胞的瘋狂生長將有極大的幫助。
結語:柳暗花明又一村
這項對「補償性增生」路徑的重大發現,無疑讓生物醫學界感到「如獲至寶」。雖然從基礎科學研究到實際臨床應用還有很長的一段路要走,但至少我們已經掌握了地圖。這再次證明了,只要科學家抱持著「打破砂鍋問到底」的精神,即使是困擾了半個世紀的謎團,終究會有真相大白的一天。
在這個科技日新月異的時代,我們每天都在見證奇蹟。或許在不久的將來,人類組織的自我修復將不再依賴緩慢的自然過程,而是能像電腦更新程式一樣,快速地完成「重新啟動」。讓我們拭目以待這項研究將如何徹底翻轉人類的醫療未來!